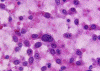
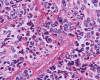
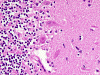
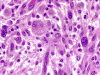

OU Pathology NeuroLearn
For Medical Students & Residents
Department of Pathology, University of Oklahoma Health Sciences Center, Oklahoma City, OK, U.S.A.
This program is intended only for educational purposes and not for diagnostic, research, or therapeutic purposes. Copy rights reserved.
| About Us |
| Technical Information |
| Contact Us |
Neuropathology Quizzes
| Quiz
set #1: Cytologic preparations Contributed by Kwok Ling Kam, M.B., B.S., Kar-Ming Fung, M.D., Ph.D. |
 NQ-001 |
 NQ-002 |
 NQ-003 |
 NQ-004 |
 NQ-005 |
 NQ-006 |
 NQ-007 |
 NQ-008 |
 NQ-009 |
 NQ-010 |
NQ-011 |
 NQ-012 |
 NQ-013 |
 NQ-014 |
 NQ-015 |
 NQ-016 |
 NQ-017 |
 NQ-018 |
 NQ-019 |
 NQ-020 |
|
Quiz
set #2: Tumor Go to top of the page Contributed by Kwok Ling Kam, M.B., B.S., Kar-Ming Fung, M.D., Ph.D. |
 NQ-021 |
 NQ-022 |
 NQ-023 |
 NQ-024 |
 NQ-025 |
 NQ-026 |
 NQ-027 |
 NQ-028 |
 NQ-029 |
 NQ-030 |
 NQ-031 |
 NQ-032 |
 NQ-033 |
 NQ-034 |
 NQ-035 |
 NQ-036 |
NQ-037 |
 NQ-038 |
 NQ-039 |
 NQ-040 |
|
Quiz
set #3: Gross Pathology Go to top of the page Contributed by Kar-Ming Fung, M.D., Ph.D. |
 NQ-041 |
 NQ-042 |
 NQ-043 |
 NQ-044 |
 NQ-045 |
 NQ-046 |
 NQ-047 |
 NQ-048 |
 NQ-049 |
 NQ-050 |
 NQ-051 |
 NQ-052 |
|
NQ-053 |
 NQ-054 |
NQ-055 |
 NQ-056 |
 NQ-057 |
 NQ-058 |
 NQ-059 |
NQ-060 |
|
Quiz
set #4: Muscle and peripheral nerve Go to top of the page Contributed by Kar-Ming Fung, M.D., Ph.D. |
 NQ-061 |
 NQ-062 |
 NQ-063 |
 NQ-064 |
|
NQ-065 |
 NQ-066 |
 NQ-067 |
 NQ-068 |
 NQ-069 |
 NQ-070 |
 NQ-071 |
 NQ-072 |
 NQ-073 |
 NQ-074 |
 NQ-075 |
NQ-076 |
 NQ-077 |
 NQ-078 |
 NQ-079 |
 NQ-080 |
|
Quiz
set #5: Tumor Go to top of the page Contributed by Kar-Ming Fung, M.D., Ph.D. |
 NQ-081 |
 NQ-082 |
 NQ-083 |
 NQ-084 |
 NQ-085 |
 NQ-086 |
 NQ-087 |
 NQ-088 |
 NQ-089 |
NQ-090 |
NQ-091 |
 NQ-092 |
 NQ-093 |
NQ-094 |
 NQ-095 |
 NQ-096 |
 NQ-097 |
 NQ-098 |
 NQ-099 |
 NQ-100 |
|
Quiz
set #6: Miscellaneous non-neoplastic
Go to top of the page Contributed by Jo Elle Peterson, M.D. |
 NQ-101 |
 NQ-102 |
 NQ-103 |
 NQ-104 |
 NQ-105 |
 NQ-106 |
 NQ-107 |
 NQ-108 |
 NQ-109 |
 NQ-110 |
 NQ-111 |
 NQ-112 |
 NQ-113 |
 NQ-114 |
 NQ-115 |
 NQ-116 |
 NQ-117 |
 NQ-118 |
 NQ-119 |
 NQ-120 |
|
Quiz
set #7: Miscellaneous Go to top of the page Contributed by Jo Elle Peterson, M.D. |
 NQ-121 |
 NQ-122 |
 NQ-123 |
 NQ-124 |
 NQ-125 |
 NQ-126 |
 NQ-127 |
 NQ-128 |
 NQ-129 |
 NQ-130 |
 NQ-131 |
 NQ-132 |
 NQ-133 |
 NQ-134 |
 NQ-135 |
 NQ-136 |
 NQ-137 |
 NQ-138 |
NQ-139 |
 NQ-140 |
